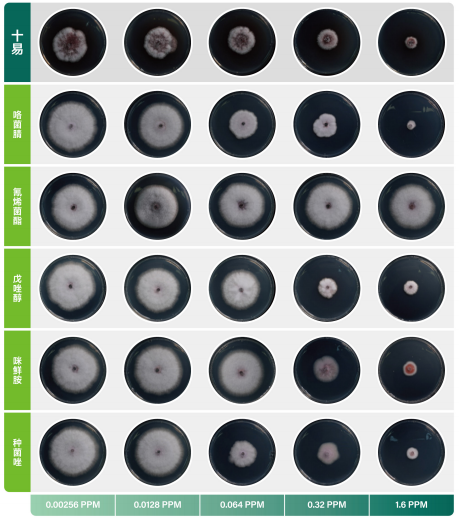

中国汽车工业协会的最新统计显示,2022年中国新能源汽车持续增长,产销分别完成705.8万辆和688.7万辆,同比分别增长96.9%和93.4%,连续8年保持全球第一。随着新能源汽车市场的不断扩大,苏州新能源充电行业也将迎来新一轮的爆发增长周期,充电桩市场空间将达到万亿,苏州市新能源产业联合会光储氢电充专委会旨在通过聚集政产学研各界资源,整合新能源汽车产业链资源,利用行业内交流调研活动,推动新能源汽车行业的技术升级和产业化发展。

日前,苏州市新能源产业联合会光储氢电充专委会成立大会召开,会上成立光伏、储能、氢能、智能电网、充电桩五大专委会。第三方充电服务运营商快电成为专委会成员,今后,快电将依托全国网络和已有运营经验,与专委会内其他成员单位共同推进新能源汽车供能行业的规范化、标准化运营。
快电城市运营中心负责人武腾飞表示:“快电在全国各地拥有较为完善的充电服务网络、丰富的建站建桩及场站管理运营经验,加入专委会之后,快电将进一步加强与各会员单位的沟通与合作,把公司在充电服务、网络建设、充电场站管理等方面的经验结合苏州本地情况进行推广,推动行业上下流融合与资源共享,探索高效供能方式与业务创新路径,与合作伙伴共建新能源汽车供能行业标准,为苏州新能源汽车行业发展助力。”
作为国内高成长潜力的电动汽车充电服务运营商之一,快电还联合战略合作伙伴能链智电(NASDAQ:NAAS)为充电场站增设共享按摩椅、小食堂、无人售货柜等非电服务设施,全方位优化新能源汽车车主的充电体验。
未来,快电还将联合各方势力推进全国充电服务网络的建设完善,持续提升电动汽车充电服务保障能力,解决新能源汽车的里程焦虑问题,从而推动新能源汽车行业的快速发展
免责声明:市场有风险,选择需谨慎!此文仅供参考,不作买卖依据。
文章投诉热线:182 3641 3660 投诉邮箱:7983347 16@qq.com